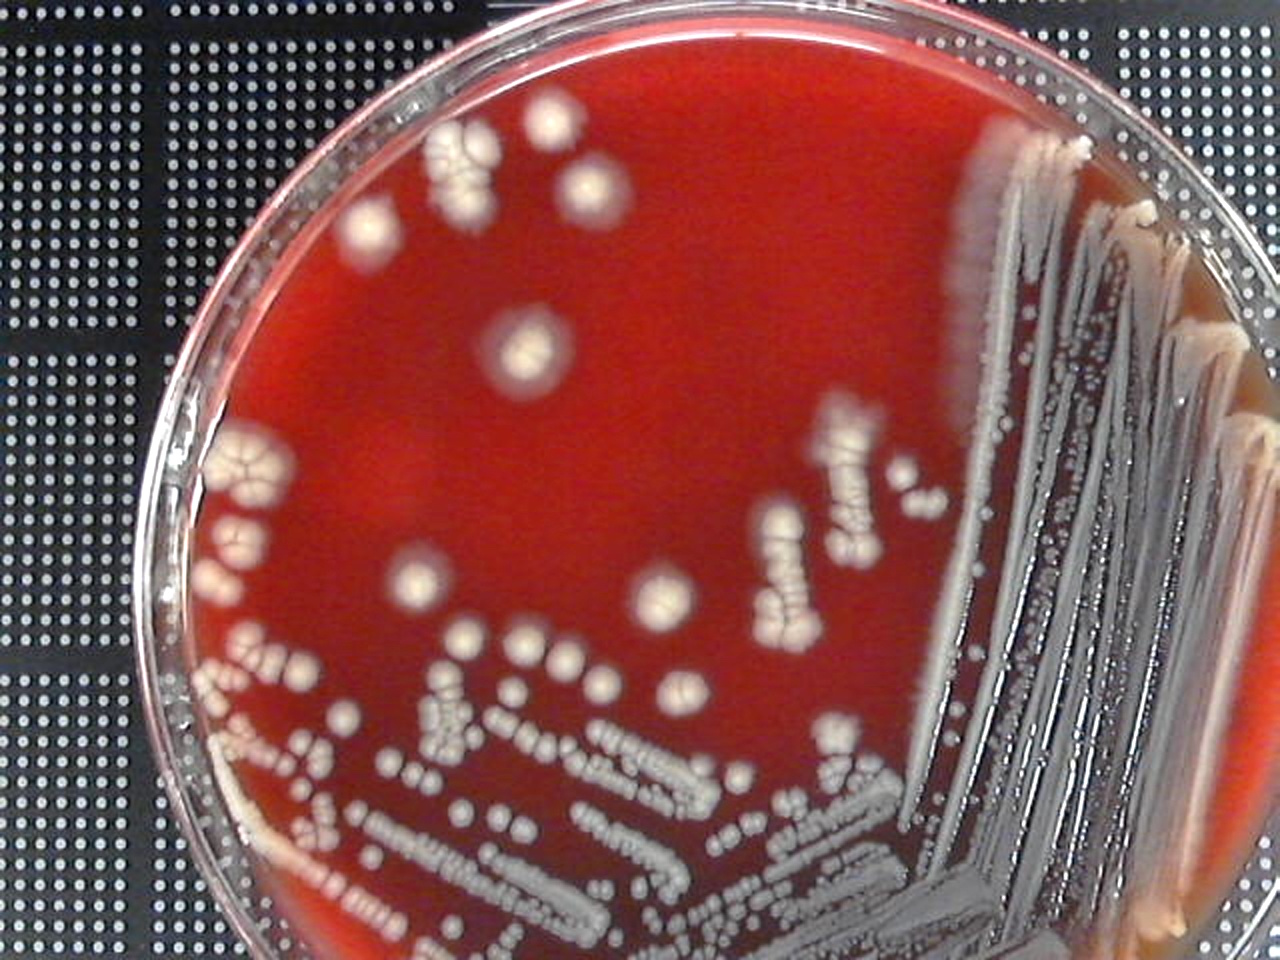

Escherichia
Escherichia coli

Incubation: Aerobic
Media: SBA
Source: Urine
Colony Morphology
Form: Round
Elevation: Raised
Margin: Entire
Color: White
Hemolysis — Gamma/None
Gram Stain
Gram Negative
Microscopic Morphology: Bacilli
Organism Size: Medium
Testing Pathway
Oxidase: Negative
Lactose Fermenter? Yes
Indole: Positive
Motility: Positive
TSI: A/A - -